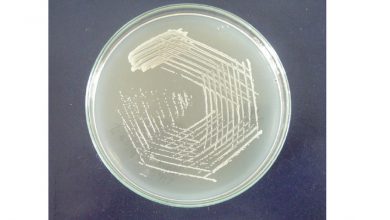
میلک آگار چیست؟ - کاربرد و ساخت آن

محیط کشت
- علوم پایه
کشت باکتری (کشت میکروبی) چیست؟ – انواع و چگونگی کشت
یکی از روش های تحقیق در زیست شناسی مولکولی روش کشت باکتری (کشت میکروبی) می باشد که در این روش…
بیشتر بخوانید » - آزمایشگاهی
میلک آگار چیست؟ – کاربرد و ساخت
یکی از انواع محیط های کشت میلک آگار است که برای بررسی تمام میکروارگانیسم هایی که در شیر و انواع…
بیشتر بخوانید » - آزمایشگاهی
محیط کشت و انواع آن در یک نگاه کوتاه و اجمالی
محیطی که در آن شرایط لازم برای رشد دادن سلول ها، میکروارگانیسم ها و حتی گیاهان کوچک به وجود می…
بیشتر بخوانید » - عمومی
محیط کشت چیست و چه کاربردی دارد؟
محیط کشت (Growth medium) یا محیط رشد یک محیط جامد ، مایع یا نیمه جامد است که برای حمایت از…
بیشتر بخوانید »